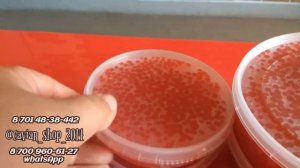
Расфасовка икры 200гр, 500гр

3:14
3:14
2024-08-13 08:58

 3:44
3:44

 3:44
3:44
2025-05-19 13:31

 4:15
4:15

 4:15
4:15
2025-09-24 15:27

 2:30
2:30

 2:30
2:30
2024-11-18 16:13

 2:03
2:03

 2:03
2:03
2024-04-24 19:10

 1:44
1:44

 1:44
1:44
2025-09-23 06:44

 2:24
2:24

 2:24
2:24
2025-09-24 14:05

 27:51
27:51

 27:51
27:51
2025-09-19 12:16

 3:46
3:46

 3:46
3:46
2023-11-20 13:41

 0:32
0:32
0:32
0:32
2024-02-03 04:41

 8:00
8:00

 8:00
8:00
2025-09-23 12:00

 1:59
1:59

 1:59
1:59
2021-10-29 12:16

 0:21
0:21

 0:21
0:21
2023-10-04 18:21

 0:53
0:53

 0:53
0:53
2023-10-07 13:26

 9:55
9:55

 9:55
9:55
2023-09-05 12:42

 4:36
4:36

 4:36
4:36
2022-09-25 10:00

 2:08
2:08

 2:08
2:08
2025-09-17 15:53

 0:53
0:53
![Сергей Завьялов - В дороге (Премьера клипа 2025)]() 3:14
3:14
![Хабибулло Хамроз - Хуп деб куёринг (Премьера клипа 2025)]() 4:04
4:04
![KhaliF - Где бы не был я (Премьера клипа 2025)]() 2:53
2:53
![Алмас Багратиони - Сила веры (Премьера клипа 2025)]() 3:18
3:18
![ARTEE - Лети (Премьера клипа 2025)]() 3:13
3:13
![Ислам Итляшев - Не вспоминай (Премьера клипа 2025)]() 2:52
2:52
![Жалолиддин Ахмадалиев - Тонг отгунча (Премьера клипа 2025)]() 4:44
4:44
![Игорь Крутой - Зонтик (Премьера клипа 2025)]() 4:00
4:00
![Джатдай - Забери печаль (Премьера клипа 2025)]() 2:29
2:29
![Азимжон Сайфуллаев - Тупрок буламиз (Премьера клипа 2025)]() 4:38
4:38
![Фаррух Хамраев - Отажоним булсайди (Премьера клипа 2025)]() 3:08
3:08
![Любовь Попова - Прощай (Премьера клипа 2025)]() 3:44
3:44
![Сергей Одинцов - Девочка любимая (Премьера клипа 2025)]() 3:56
3:56
![Зафар Эргашов & Фируз Рузметов - Лабларидан (Премьера клипа 2025)]() 4:13
4:13
![Magas - Без тебя (Премьера клипа 2025)]() 2:28
2:28
![Дана Лахова - Одинокая луна (Премьера клипа 2025)]() 2:15
2:15
![Сардор Расулов - Етолмадим (Премьера клипа 2025)]() 4:15
4:15
![Аля Вайш - По кругу (Премьера клипа 2025)]() 2:37
2:37
![Анна Бершадская - Новая я (Премьера клипа 2025)]() 2:41
2:41
![Зара - Танго о двух влюбленных кораблях (Премьера клипа 2025)]() 3:10
3:10
![Только ты | All of You (2025)]() 1:38:22
1:38:22
![Чумовая пятница 2 | Freakier Friday (2025)]() 1:50:38
1:50:38
![Когда ты закончишь спасать мир | When You Finish Saving the World (2022)]() 1:27:40
1:27:40
![F1 (2025)]() 2:35:53
2:35:53
![Плохие парни 2 | The Bad Guys 2 (2025)]() 1:43:51
1:43:51
![Терминатор 2: Судный день | Terminator 2: Judgment Day (1991) (Гоблин)]() 2:36:13
2:36:13
![Обитель | The Home (2025)]() 1:34:43
1:34:43
![Положитесь на Пита | Lean on Pete (2017)]() 2:02:04
2:02:04
![Хищник | Predator (1987) (Гоблин)]() 1:46:40
1:46:40
![Дом из динамита | A House of Dynamite (2025)]() 1:55:08
1:55:08
![Государственный гимн | Americana (2025)]() 1:47:31
1:47:31
![Тот самый | Him (2025)]() 1:36:20
1:36:20
![Девушка из каюты №10 | The Woman in Cabin 10 (2025)]() 1:35:11
1:35:11
![Мужчина у меня в подвале | The Man in My Basement (2025)]() 1:54:48
1:54:48
![Порочный круг | Vicious (2025)]() 1:42:30
1:42:30
![Эффект бабочки | The Butterfly Effect (2003)]() 1:53:35
1:53:35
![Дикари | The Savages (2007)]() 1:54:19
1:54:19
![Сумерки | Twilight (2008)]() 2:01:55
2:01:55
![Лос-Анджелес в огне | Kings (2017)]() 1:29:27
1:29:27
![Элис, дорогая | Alice, Darling (2022)]() 1:29:30
1:29:30
![МегаМен: Полный заряд Сезон 1]() 10:42
10:42
![Крутиксы]() 11:00
11:00
![Врумиз. 1 сезон]() 13:10
13:10
![МиниФорс]() 0:00
0:00
![Тодли Великолепный!]() 3:15
3:15
![Агент 203]() 21:08
21:08
![Команда Дино Сезон 1]() 12:08
12:08
![Истории Баданаму Сезон 1]() 10:02
10:02
![Пластилинки]() 25:31
25:31
![Карли – искательница приключений. Древнее королевство]() 13:00
13:00
![Супер Дино]() 12:41
12:41
![Корги по имени Моко. Домашние животные]() 1:13
1:13
![Умка]() 7:11
7:11
![Сборники «Приключения Пети и Волка»]() 1:50:38
1:50:38
![Пиратская школа]() 11:06
11:06
![Шахерезада. Нерассказанные истории Сезон 1]() 23:53
23:53
![Сборники «Зебра в клеточку»]() 45:30
45:30
![Приключения Пети и Волка]() 11:00
11:00
![Новое ПРОСТОКВАШИНО]() 6:30
6:30
![Артур и дети круглого стола]() 11:22
11:22

 0:53
0:53Скачать видео
| 256x144 | ||
| 640x360 |
 3:14
3:14
2025-10-29 10:28
 4:04
4:04
2025-10-28 13:40
 2:53
2:53
2025-10-28 12:16
 3:18
3:18
2025-10-24 12:09
 3:13
3:13
2025-10-18 09:47
 2:52
2:52
2025-10-28 10:47
 4:44
4:44
2025-10-19 10:46
 4:00
4:00
2025-10-18 10:19
 2:29
2:29
2025-10-24 11:25
 4:38
4:38
2025-10-23 11:27
 3:08
3:08
2025-10-18 10:28
 3:44
3:44
2025-10-21 09:25
 3:56
3:56
2025-10-28 11:02
 4:13
4:13
2025-10-29 10:10
 2:28
2:28
2025-10-17 12:00
 2:15
2:15
2025-10-22 14:16
 4:15
4:15
2025-10-26 12:52
 2:37
2:37
2025-10-23 11:33
 2:41
2:41
2025-10-22 14:02
 3:10
3:10
2025-10-27 10:52
0/0
 1:38:22
1:38:22
2025-10-01 12:16
 1:50:38
1:50:38
2025-10-16 16:08
 1:27:40
1:27:40
2025-08-27 17:17
 2:35:53
2:35:53
2025-08-26 11:45
 1:43:51
1:43:51
2025-08-26 16:18
 2:36:13
2:36:13
2025-10-07 09:27
 1:34:43
1:34:43
2025-09-09 12:49
 2:02:04
2:02:04
2025-08-27 17:17
 1:46:40
1:46:40
2025-10-07 09:27
 1:55:08
1:55:08
2025-10-29 16:30
 1:47:31
1:47:31
2025-09-17 22:22
 1:36:20
1:36:20
2025-10-09 20:02
 1:35:11
1:35:11
2025-10-13 12:06
 1:54:48
1:54:48
2025-10-01 15:17
 1:42:30
1:42:30
2025-10-14 20:27
 1:53:35
1:53:35
2025-09-11 08:20
 1:54:19
1:54:19
2025-08-27 18:01
 2:01:55
2:01:55
2025-08-28 15:32
 1:29:27
1:29:27
2025-08-28 15:32
 1:29:30
1:29:30
2025-09-11 08:20
0/0
2021-09-22 21:43
 11:00
11:00
2022-07-25 18:59
2021-09-24 16:00
 0:00
0:00
2025-10-30 08:37
 3:15
3:15
2025-06-10 13:56
 21:08
21:08
2025-01-09 16:39
2021-09-22 22:29
2021-09-22 21:29
 25:31
25:31
2022-04-01 14:30
 13:00
13:00
2024-11-28 16:19
 12:41
12:41
2024-11-28 12:54
 1:13
1:13
2024-11-29 14:40
 7:11
7:11
2025-01-13 11:05
 1:50:38
1:50:38
2025-10-29 16:37
 11:06
11:06
2022-04-01 15:56
2021-09-22 23:25
 45:30
45:30
2025-09-17 18:49
 11:00
11:00
2022-04-01 17:59
 6:30
6:30
2018-04-03 10:35
 11:22
11:22
2023-05-11 14:51
0/0

